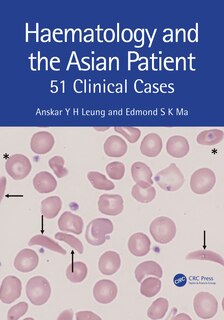
Couverture_Haematology and the Asian Patient

Aperçu gratuit du livre Haematology and the Asian Patient: 51 Clinical Cases
133,50 $
Prix en ligne. Les prix et les offres peuvent différer en magasin.

M’expédier cet article
Vérification des stocks…
Acheter maintenant et ramasser en magasin
Vérification des stocks…
Trouver en magasin
Vérification des stocks…
Description
Publié par: CRC Press
Dimensions à l’expédition: 10" H x 7" W x 1" L
ISBN: 9781032351254
Étape de vie: null
Cotes et évaluations
Évaluation éditoriale
D’autres ont aussi acheté
Haematology and the Asian Patient: 51 Clinical Cases
/fr-ca/haematology-and-the-asian-patient-51-clinical-cases/F0897253-0293-4EB5-A524-73E97F39B3F1.html
F0897253-0293-4EB5-A524-73E97F39B3F1
Haematology and the Asian Patient: 51 Clinical Cases
https://dynamic.indigoimages.ca/v1/books/books/103235125X/1.jpg
133.5
Haematology and the Asian Patient: 51 Clinical Cases
https://dynamic.indigoimages.ca/v1/books/books/1032351268/1.jpg
347.95
Haematology and the Asian Patient: 51 Clinical Cases
https://dynamic.indigoimages.ca/v1/https://cdn.kobo.com/book-images/Images/0e20a855-406f-47ff-886d-ac7300713aad/300/300/False/image.jpg
97.99